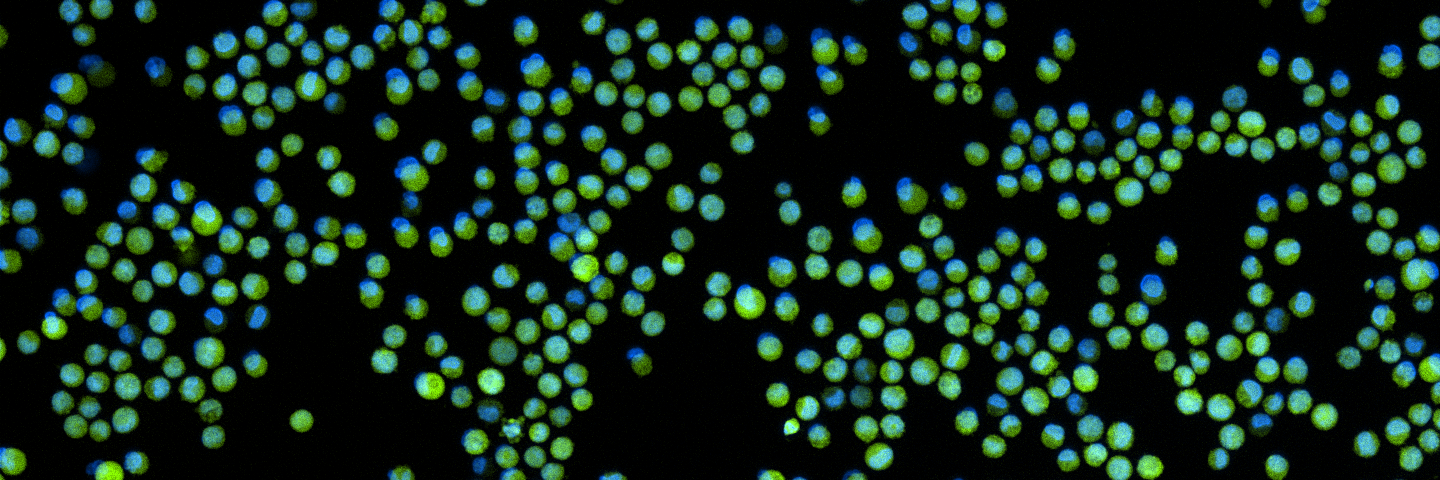
Human Cell STR Testing | ATCC

Str Profiling Kit
Examine the stunning technical aspects of Str Profiling Kit with substantial collections of detailed images. illustrating the mechanical aspects of photography, images, and pictures. perfect for technical documentation and manuals. Our Str Profiling Kit collection features high-quality images with excellent detail and clarity. Suitable for various applications including web design, social media, personal projects, and digital content creation All Str Profiling Kit images are available in high resolution with professional-grade quality, optimized for both digital and print applications, and include comprehensive metadata for easy organization and usage. Explore the versatility of our Str Profiling Kit collection for various creative and professional projects. Our Str Profiling Kit database continuously expands with fresh, relevant content from skilled photographers. Comprehensive tagging systems facilitate quick discovery of relevant Str Profiling Kit content. Diverse style options within the Str Profiling Kit collection suit various aesthetic preferences. Each image in our Str Profiling Kit gallery undergoes rigorous quality assessment before inclusion. Multiple resolution options ensure optimal performance across different platforms and applications. The Str Profiling Kit collection represents years of careful curation and professional standards. Cost-effective licensing makes professional Str Profiling Kit photography accessible to all budgets. Whether for commercial projects or personal use, our Str Profiling Kit collection delivers consistent excellence.








![[ATCC] Mouse & Human Cell STR Profiling Service는 ATCC에 의뢰하세요 | 코람바이오텍(주 ...](https://www.korambiotech.com/wp-content/uploads/2022/02/ATCC-Mouse-STR-service.jpg)














![[ATCC] Mouse & Human Cell STR Profiling Service는 ATCC에 의뢰하세요 | 코람바이오텍(주 ...](https://www.korambiotech.com/wp-content/uploads/2022/02/600x600-mouse-STR-service-01.jpg)
























![Figure 3. [Example of Human STR Profile...]. - Assay Guidance Manual ...](https://www.ncbi.nlm.nih.gov/sites/books/NBK144066/bin/dnaprofiling-Image003.jpg)